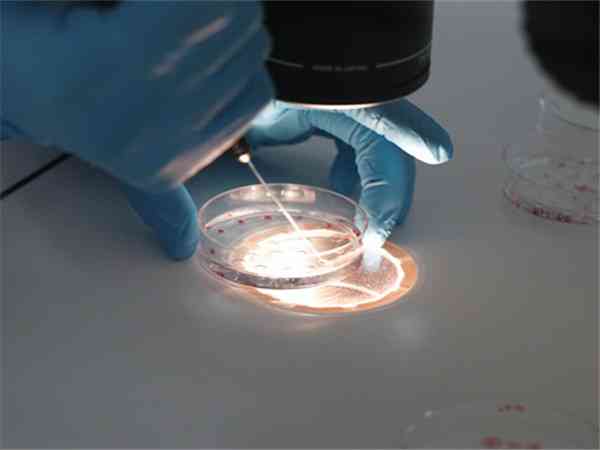

单身试管婴儿

国内单身试管婴儿医院真没有,要想助孕还得远赴海外
在国内单身是不能做试管婴儿的,如果想做试管婴儿只有去国外。我国对试管婴儿的管控非常严格,必须是我国合法夫妻携带结婚证、身份证、准生证等才可去医院做试管婴儿。如果没有结婚证的话,大家可以考虑去美国、俄罗斯、泰国、丹麦等,一些允许单身做试管的国家,不过其费用的话肯定是比国内高很多的,大家在去前一定要准备好充足的资金。未婚目前在我国所有的公立医院都是不可以做试管婴儿的,在国内所有的公立医院做试管都是必须...
泰国三代试管婴儿费用大曝光,生男孩花费明细快看这里
试管婴儿技术诞生至今已超过40年,每个国家该方面的技术也都是比较成熟的。泰国就是其中一个,从第一代试管,第二代试管技术到目前的第三代试管婴儿技术,现在泰国第三代试管婴儿的成功率高达75%。在泰国做一次试管婴儿的费用在15-20万左右,具体的费用还要根据治疗的病人为准,如果治疗不顺利,费用会相应增加。如果想要生男孩,具体情况请咨询泰国医院。泰国生男孩做第三代试管婴儿价格:其实泰国做三代试管没有禁止选...

俄罗斯单身试管婴儿花费参考,2024助孕费用明细一览
俄罗斯单身女性做一次试管的费用项目要比已婚的多。一般来说,其费用项目大致就包括了术前检查费用、促排卵费用、取卵移植费用、胚胎检测费用(适用于三代试管),其费用大致就在3-10万元左右,而单身女性做试管还需要增加一项试管供精的费用,大概在25000元,其总费用就在5-13万元左右。当然由于试管女性生理年龄不同,其试管助孕费用也就会存在一定的差异。俄罗斯试管助孕费用明细表由于俄罗斯允许单身人士利用试管...

国外单身试管婴儿所发证件参考,出生医学证明在其中
在国内做试管结婚证会查真伪不要蒙混过关,而在国外做单身试管婴儿,以俄罗斯试管婴儿为例,只要办理完相关手续,可以出具相应出生医学证明,至于其他国家有没有出生证明需要具体咨询生殖医院医生。国人出国做单身试管婴儿一般会有相关出生证明,以俄罗斯为例,出国试管求子需要办理两个手续,一个是试管婴儿出境手续,另一个是单身试管婴儿上户口手续。在俄罗斯做单身试管婴儿,宝宝出生后,需要飞往莫斯科并停留至少15天,才能...

国内试管婴儿助孕标准参考,单身试管、生混血儿皆不可
在生活中,单身妈妈做试管生下混血宝宝成功的案例有很多,但是这些单身妈妈几乎都是在外国做的试管婴儿。很多人就好奇,在中国能不能做试管婴儿生混血宝宝,其实我国做试管婴儿要求是非常严格的,需要提供准生证,结婚证,夫妻相关证件才可以在国内做试管婴儿。单身女性是不能在国内做的,已婚女性也要满足条件,还有国内禁止精子买卖,申请精子库精子要看有没有混血精子。中国可不可以做混血试管婴儿:试管婴儿技术迅速发展,解决...

没结婚的人不可以做试管婴儿,未婚助孕问题比你想得多
国内目前是不允许单身人士做试管,在做试管的时候会有医生对患者的情况进行严格的审核,其中有一项就是证件证明,需要使用到结婚证、身份证和准生证,因为试管涉及到伦理道德的问题,所以没有办法申请供卵或者供精,所以说为了不破坏社会的规律,不允许未婚人生做试管。未婚能不能做试管婴儿社会观念的改变,婚姻再不是必不可少,越来越多的年轻人选择单身的生活,但是养儿防老的挂念在中国人心中根深蒂固,即使很多人选择单身,但...

2024单身做试管婴儿合法国家分享,别只知道美国这一个
国内是不允许单身做试管的,但是国内却有很多国家是合法的,其中比较热门的包括美国、俄罗斯、格鲁吉亚等等,这些国家试管婴儿技术也比较成熟,对辅助生殖政策较为开放,因此很多同性恋人、单身的女性都会选择去这些国家做试管婴儿,以下为大家详细介绍:美国目前国内单身女性去美国做试管的有很多,试管技术方面比国内更好,需要注意的是,美国不同州的政策不一样,比如加州、伊利诺伊州、内华达州等是明确允许的,其他的则要看具...

2024美国试管婴儿法规解读,单身助孕合不合法一文知晓
2022单身人士去美国做试管婴儿属于一种合法行为。美国属于人权主义国家,在这里通过试管婴儿技术进行助孕是没有任何身份以及地位的限制的,换句话说就是,无论你属于单身人士、未婚人士、不明原因难孕人士、染色体异常人士还是男/女同性恋等,都可以通过通过试管技术来实现生育的愿望,从而获得属于自己的宝宝,因此单身人士去美国做试管婴儿合法。姐妹经验分享相信很多人都知道,在我国做试管婴儿必须要提供相应的证件,即结...

俄罗斯试管婴儿的优势分享,单身助孕政策很宽松
在中国单身女性做试管婴儿确实是不合法的,而在俄罗斯单身女性做试管婴儿有政策法律的优势。在俄罗斯做试管婴儿无需我们国内的“三证”并且无论是单身男性、单身女性或是同性,都可以通过试管婴儿来获得属于自己的宝宝。只需要办好护照,然后前往驻国内的俄罗斯大使馆办理签证,就能去俄罗斯做试管婴儿了。在俄罗斯单身女性做试管婴儿除了政策优势还有其他很多优势,下面就列举说明一下:试管婴儿技术优势,俄罗斯第三代试管技术可...

单身试管婴儿落户解答,没出生证明可以这样办理
目前有很多单身的女性想要去国外做试管生孩子,但是成功怀孕后回国会涉及到宝宝上户口的问题,这就是一件不容易的事情,目前很多单身女性表示无法给宝宝上户口,因为会要求出生出生证明,本文整理了单身试管落户的技巧,供各位参考。单身试管婴儿能不能上户口根据我国《婚姻法》第二十五条规定:非婚生子女享有与婚生子女同等的权利,任何人不得加以危害和歧视。因此即使是非婚生子女也与已婚生长女拥有同样的权力,给孩子上户口是...

俄罗斯单身试管婴儿机构分享,未婚女性推荐3家做三代助孕
单身未婚女性可以到俄罗斯做第三代试管婴儿,而俄罗斯单身试管婴儿助孕机构有很多家,其中Rosjurconsulting、AVA-Peter和Medsi等机构备受推荐。这些机构设备先进、专业医师众多、治疗方案科学合理,并且提供优质服务。他们的三代试管婴儿成功率高达70%以上,价格也相对合理,是单身女性值得信赖的选择。俄罗斯试管婴儿私立机构推荐RosjurconsultingRosjurconsulti...

单身女性在台湾做试管婴儿需要满足哪些条件才能申请?
台湾不允许单身女性做试管婴儿,在台湾做试管婴儿需要提供结婚证、准生证、夫妻双方不孕不育证明才可以。台湾拥有全球先进的冻卵冻精冻胚胎技术,第3代试管婴儿技术起步早,技术发达,成功率高达80%。在此基础上同美国相比,赴台的费用要远远低于美国,所以相对来说,台湾三代试管婴儿比美国性价比高但次于泰国。有下面情况的不孕不育患者可以进行台湾试管婴儿手术:双侧输卵管不通:无论是炎症、结核或者是子宫内膜异位使输卵...